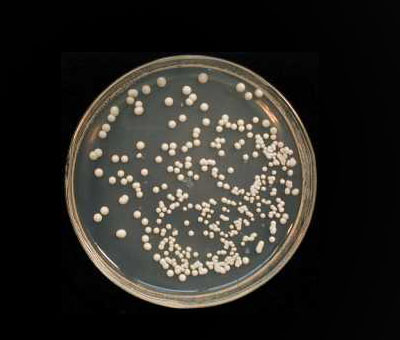
p>酵母多元培养基是指结合发酵需求,菌种特性,培养基营养需求,产品的

发酵培养基

乳糖复发酵培养基lactosebrothhb0111250g
图片尺寸1000x749
液体培养基
图片尺寸634x430
甘露醇发酵培养基
图片尺寸570x474
p>酵母多元培养基是指结合发酵需求,菌种特性,培养基营养需求,产品的
图片尺寸400x340
乳糖胆盐发酵培养基(发酵管)培养基 250g 化学试剂 实验用品
图片尺寸1440x1920
海博乳糖胆盐发酵培养基100克250g食品大肠菌检验其它
图片尺寸800x800
多价蛋白胨-酵母膏(py)培养基用于产气荚膜梭菌糖(醇)发酵的基础培养
图片尺寸447x422
葡萄糖发酵培养基250g杭州微生物m0014
图片尺寸800x800
【【三顺教学仪器】乳糖胆盐发酵培养基 br 250g/瓶】图片
图片尺寸601x800
cm108乳糖胆盐发酵培养基/gcm108乳糖胆盐发酵培养基(颗粒剂型)
图片尺寸780x778
环凯乳糖胆盐发酵培养基 250g/瓶 货号022040/041 发酵培养基包邮
图片尺寸800x800
乳糖复发酵培养基 250g/瓶 杭州微生物 m0226大肠群菌的确证试
图片尺寸800x800
乳糖胆盐发酵培养基 br250g/瓶 广东环凯
图片尺寸500x371
甘露醇发酵培养基250g金黄色葡萄球菌发酵试验024030环凯
图片尺寸800x800
化科(chem sci)乳糖发酵培养基 250g lactose broth
图片尺寸800x800
生化试剂 甘露醇发酵培养基 br250g/瓶 北京奥博星
图片尺寸601x852
乳糖胆盐发酵培养基
图片尺寸660x495
北京鸿润宝顺生产 发酵培养基 量大包邮 植物氮源大豆蛋白胨
图片尺寸750x1050
乳糖胆盐发酵培养基250g 食品检验微生物培养基饮用水及水源_不打折
图片尺寸750x750
乳糖胆盐发酵培养基 250g 广东
图片尺寸800x800